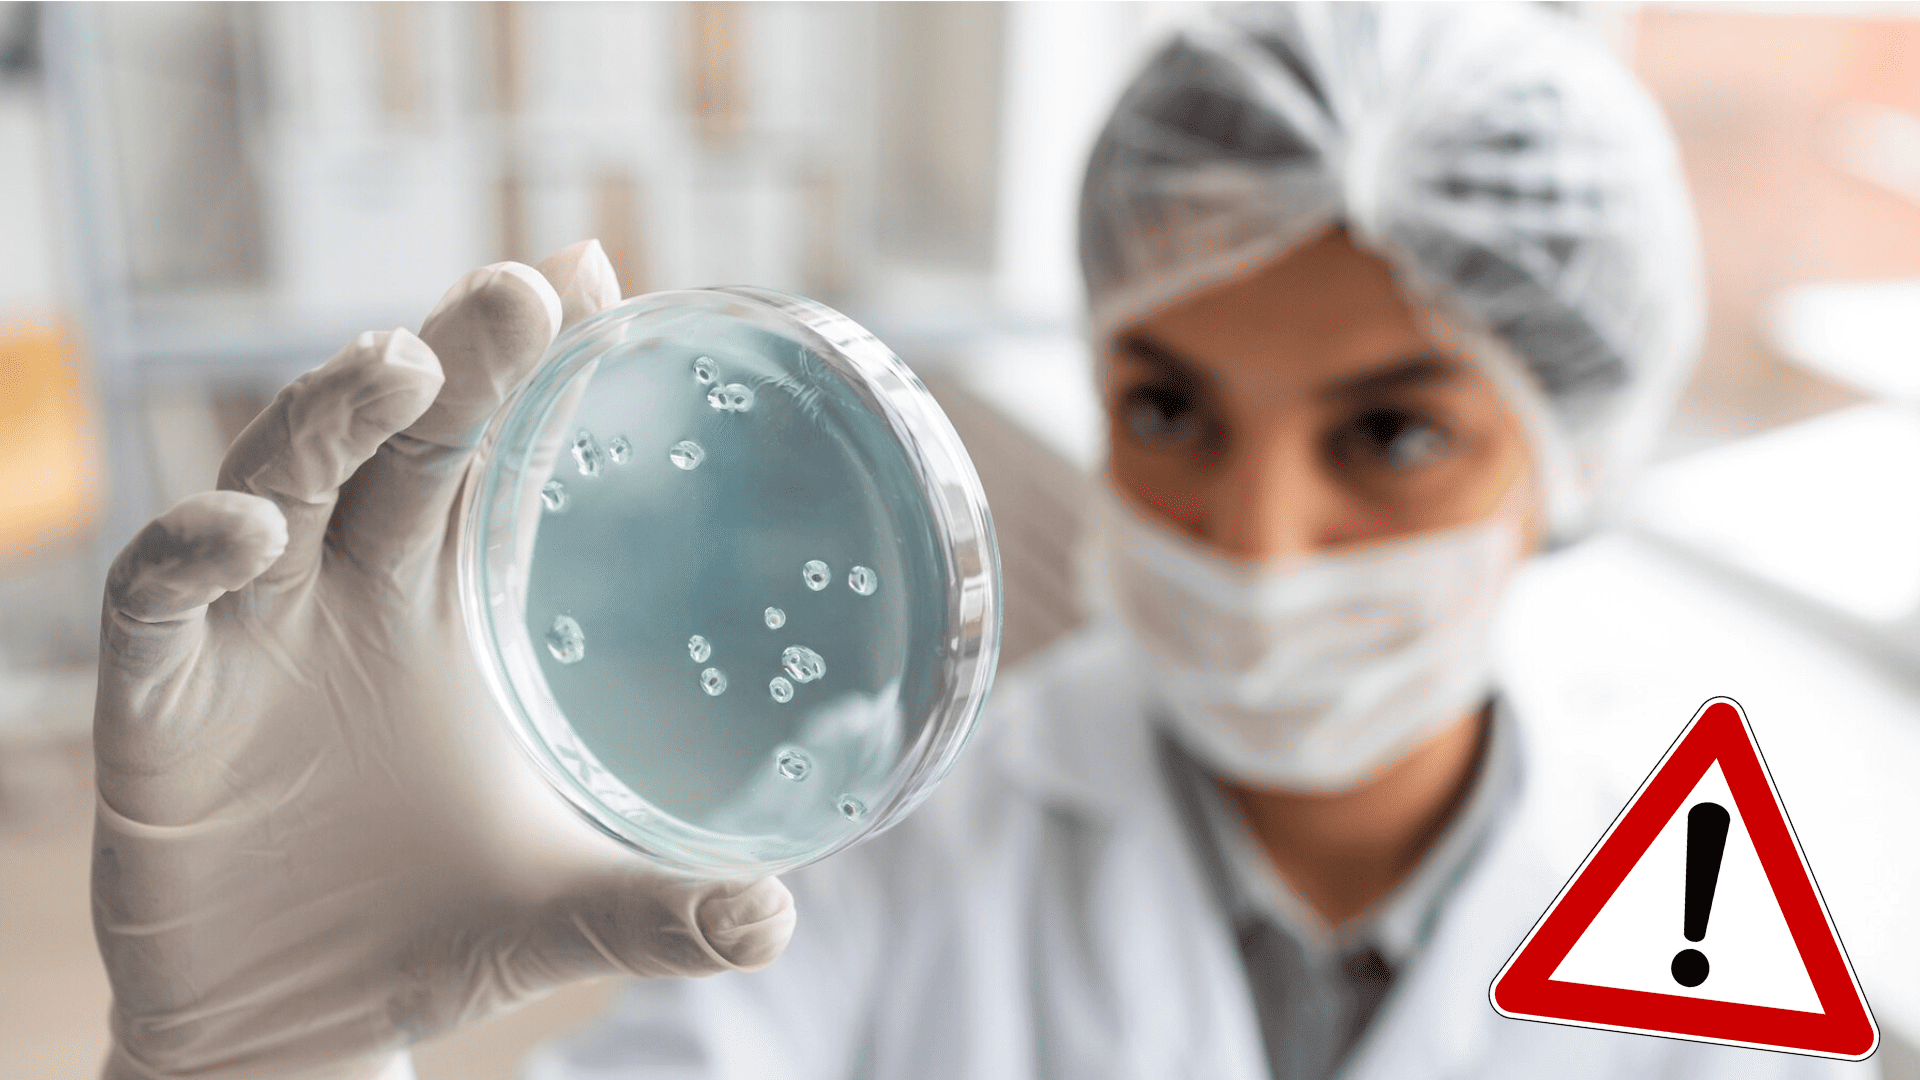
Žena drží v ruke laboratórnu vzorku.

Ľudí znepokojuje nový variant koronavírusu Pirola. Na stole sú aj obavy z výrazného nárastu nakazených
- Počet nakazených koronavírusom opäť stúpa
- Najčastejším variantom je aktuálne nový BA.2.86 s názvom pirola
Jesenné počasie dáva po zdravotnej stránke zabrať mnohým ľuďom. Ako informuje portál TV Nova, postupne pribúda počet prípadov nakazených koronavírusom, pričom sa skloňuje najčastejšie nový variant BA.2.86 s názvom pirola.
Pirola je podľa denníka The Mirror aktuálne na ceste k tomu stať sa dominantným variantom vo Veľkej Británii. Práve tam už nový variant prenikol a bol detegovaný v laboratórnych vzorkách.
Zatiaľ boli potvrdené len desiatky prípadov. Informovala o tom Národná zdravotná služba (NHS), ktorá sa však obáva výrazného nárastu a tlaku na zdravotný systém.
Zoznam príznakov
NHS na svojich webových stránkach počas uplynulých dní zverejnila aktualizovaný zoznam príznakov koronavírusu.
Aktualizovaný zoznam príznakov koronavírusu od NHS:
- nepretržitý kašeľ,
- teplota, horúčka alebo zimnica,
- strata či zmena chuti alebo čuchu,
- dýchavičnosť,
- nevysvetliteľná únava, nedostatok energie,
- bolesti svalov, ktoré nie sú spôsobené cvičením,
- nechuť,
- dlhotrvajúce bolesti hlavy,
- bolesť v krku, zapchatý nos alebo nádcha,
- zvracanie,
- pocit choroby.
Podľa odborníkov nie potrebné ohľadom piroly panikáriť.
„Zatiaľ neexistuje žiadny dôkaz, ktorý by naznačoval, že BA.2.86 (pirola, pozn. red.) spôsobí vážnejšie ochorenie ako iné varianty omikronu, ktoré sú v obehu,“ cituje web Euronews profesorku a hlavnú poradkyňu v Agentúre pre zdravotnú bezpečnosť Spojeného kráľovstva Susan Hopkinsovú.
Šírenie subvariantu
U našich českých susedov zatiaľ pirola zachytená ešte nebola. Ako informuje Štátny zdravotný ústav (SZÚ), k 2. októbru mal tento variant viac ako 35 mutácií oproti aktuálne najbežnejšiemu variantu omikronu.
Počty detekcie nového variantu podľa odborníkov dokonca klesajú, no na obzore je ďalší problém. „Pozornosť budí šírenie nového subvariantu HV.1,“ píše v správe SZÚ.
Znepokojujúca svetová situácia
Svetová zdravotnícka organizácia (WHO) vyjadrila pred blížiacou sa zimou znepokojenie nad nárastom počtu nových prípadov nákazy koronavírusom vo viacerých krajinách. TASR o tom informuje na základe stredajšej správy agentúry DPA.
V krajinách, ktoré WHO nahlásili novonakazených, sa zvýšil počet hospitalizovaných s ochorením COVID-19 na jednotkách intenzívnej starostlivosti (JIS). V stredu na to upozornil v Ženeve generálny riaditeľ WHO Tedros Adhanom Ghebreyesus, pričom nie všetky krajiny nové prípady nahlasujú.
Podiel zaočkovaných ľudí proti covidu vo vysoko rizikových skupinách je podľa WHO v Amerike a Európe znepokojujúco nízky.
„COVID-19 síce nepredstavuje takú akútnu krízu ako pred dvoma rokmi, ale to neznamená, že môžeme túto chorobu ignorovať,“ dodal.

Technická riaditeľka WHO pre COVID-19 Maria Van Kerkhoveová pripomenula, že podľa doterajších štúdií v súčasnosti šíriace sa varianty vírusu nespôsobujú závažnejší priebeh ochorenia. Vlády by podľa nej mali pokračovali v testovaní, aby bolo možné ich šírenie sledovať.
Zdôraznila, že známe ochranné opatrenia proti infekcii sú stále účinné a mali by sa používať vrátane vetrania, dezinfekcie rúk, nosenia rúšok v preplnených miestnostiach a očkovania.
Súvislosť medzi úmrtiami a obezitou
Medzi obezitou a počtom úmrtí počas pandémie koronavírusu existuje priama súvislosť, zistili to holandskí výskumníci. V pondelok na to upozornil spravodajca TASR.
Výskum si objednala dolná komora parlamentu a zameral sa na súvislosť medzi životným štýlom a rizikom úmrtia na infekciu koronavírusom. Výskumníci nezávislého SEO Economisch Onderzoek (inštitútu pre ekonomický výskum) v rámci Amsterdamskej univerzity sa zamerali na prepojenie informácií o životnom štýle s úmrtiami pacientov na Covid-19 a to pred, počas a po skončení pandémie, uviedol spravodajský portál Dutchnews.nl.
Počas prvých dvoch rokov pandémie zomrelo v Holandsku o 30 000 ľudí viac, ako po iné roky. Vedci zistili, že 70 až 100 percent z nich malo nadváhu. Spomedzi ľudí s nadváhou bolo 57 až 84 percent aktívnych fajčiarov alebo fajčili v minulosti.
Štatistické údaje o životnom štýle zbiera Národný štatistický úrad (CBS), regionálne zdravotné rady a Inštitút verejného zdravia (RIVM). Pri úmrtnosti pacientov s ochorením Covid-19 vplyv iných faktorov, ako je konzumácia alkoholu, nedostatok pohybu a osamelosť, nebol taký výrazný ako obezita a fajčenie.
DutchNews.nl pripomenul, že holandskí lekári už počas pandémie pozorovali súvislosť medzi úmrtiami a obezitou. Zistenia, ku ktorým dospeli výskumníci zo SEO Onderzoek, použije vláda na určenie stratégie očkovania v budúcich pandémiách.
Čítaj viac z kategórie: Koronavírus
Zdroje: TV Nova, The Mirror, Euronews, TASR, SZÚ, NHS











